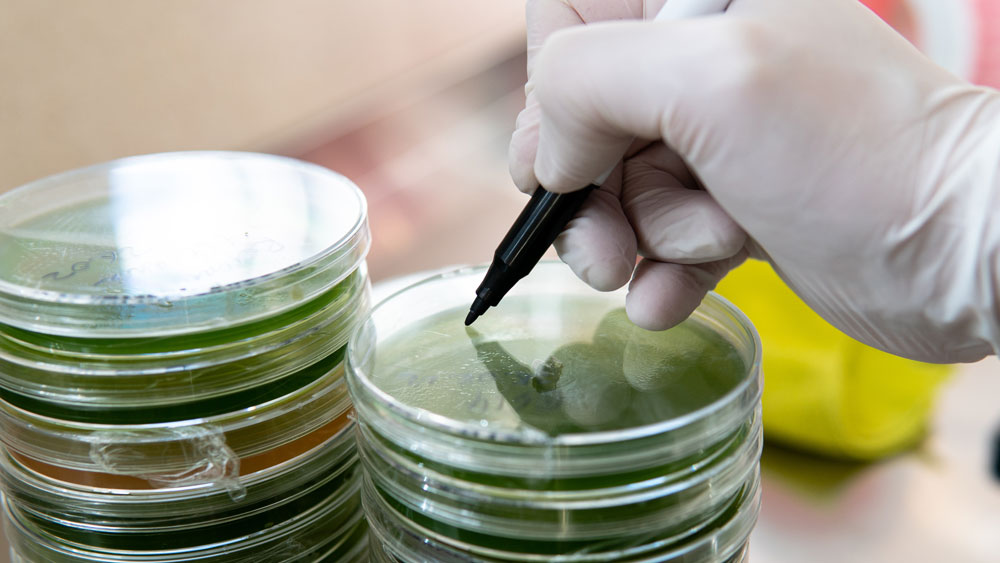
Biotalous, sienirihmasto

EU julkaisi uuden biotalousstrategian – tavoitteena EU:n kilpailukyvyn varmistaminen ja huoltovarmuuden tukeminen
Euroopan komissio on 27.11.2025 julkaissut uuden biotalousstrategian, joka korvaa vuoden 2018 linjauksen. Strategia luo kehyksen kilpailukykyiselle ja kestävälle EU:n biotaloudelle, jonka avulla pyritään vähentämään talouden riippuvuutta fossiilisista raaka-aineista ja nostamaan EU:n biopohjaisten tuotteiden arvonlisää/jalostusastetta. Strategian ydin on vauhdittaa biopohjaisten tuotteiden kehittämistä ja nopeuttaa niiden laajaa käyttöönottoa.
Komission linjaukset keskittyvät neljään pääkohtaan:
- innovaatioiden ja investointien skaalaaminen
- uusien markkinoiden luominen biopohjaisille materiaaleille ja teknologioille
- kestävän biomassan saatavuuden varmistaminen
- globaalin yhteistyön ja mahdollisuuksien hyödyntäminen
EU:n kilpailukykyä tukeva strategia on Suomessa laajasti toivottu.
"Strategia luo mahdollisuuksia maaseutualueiden elinkeinoelämän monipuolistamiselle, työpaikkojen luomiselle ja paikallisiin resursseihin perustuvien arvoketjujen kehittämiselle. Alkutuottajan asemaa tulee vahvistaa toimeenpanossa", toteaa maa- ja metsätalousministeri Sari Essayah.
Strategia siirtää painopisteen kohti teollista käyttöönottoa, markkinoiden laajentamista, kilpailukykyä ja kestävyyttä.
“Komission uusi strategia yksinkertaistaa sääntelyä ja nopeuttaa lupamenettelyjä, jotta biopohjaiset innovaatiot pääsevät markkinoille sujuvammin. Selkeät EU-tason käytännöt, kuten sääntelyhiekkalaatikot ja tekninen tuki pk-yrityksille, luovat ennakoitavan ja kilpailukykyä vahvistavan toimintaympäristön”, sanoo elinkeinoministeri Sakari Puisto.
”Suomessa on vahvat lähtökohdat vastuulliseen biopohjaisten tuotteiden kehittämiseen. Tämä on yritystemme kilpailuetu kansainvälisillä markkinoilla. Esimerkiksi biogeenisen hiilidioksidin hyödyntäminen osana vetytaloutta vauhdittaa puhdasta siirtymää, vahvistaa omavaraisuuttamme sekä edistää ilmastotavoitteiden saavuttamista”, kertoo ympäristö- ja ilmastoministeri Sari Multala.
Strategia ei tuo uusia säädöksiä, vaan varmistaa, että EU:n eri sektorien toimet tukevat yhteisiä tavoitteita eivätkä ole keskenään ristiriidassa. Komissio aikoo perustaa uusia välineitä, kuten työryhmiä, vahvistaakseen biotalouden asemaa EU:n politiikassa. Uusi strategia nähdään myös vastauksena EU:n huoltovarmuuden haasteisiin.
Biotalous kattaa monipuolisia toimintoja, jotka ulottuvat maataloudesta metsien biomassan jalostamiseen materiaaleiksi ja tuotteiksi sekä bioteknologian hyödyntämiseen. Uusi strategia tukee EU:n strategista autonomiaa, ilmastotavoitteita sekä vahvistaa resurssitehokkuutta ja biodiversiteettiä.
Lisätiedot:
erityisasiantuntija Ulla Palander, TEM, p. 029 504 9235
biotalousneuvos Anne Vehviläinen, MMM, p. 029 516 2236
